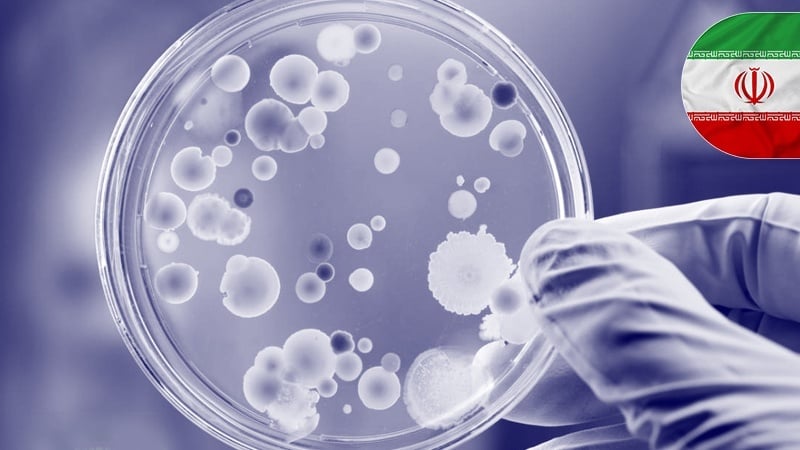

科学 | 伊朗工业的纳米飞跃:实现广泛应用纳米材料的批量生产 |揭示癌症持久免疫的奥秘
九月 29, 2025 14:20 Asia/Shanghai
-
伊朗工业的纳米飞跃:实现广泛应用纳米材料的批量生产
伊朗华语台消息: 一家知识型企业成功开发出创新产品,可应用于化妆品、纺织和塑料等多个行业。
据今日帕尔斯(Parstoday)援引梅赫尔通讯社报道:伊朗知识型企业光明能源探索公司通过批量生产多种纳米材料,在满足伊朗国内产业需求方面迈出了一大步。该公司目前生产并上市销售硒纳米颗粒、氧化锌和胶体银等纳米材料。据宣布,该公司的氧化锌纳米颗粒月产能为2吨,胶体银月产能达100吨。该公司的产品还包括二硫酸硒纳米颗粒,以胶体形式生产,应用于洗发水制造业。该公司的另一款值得关注的产品是名为纳米克丽尼亚的消毒液,采用银和氧化锌纳米粒子制备。
揭示癌症持久免疫的奥秘
新研究表明,一种名为干细胞样T细胞的特殊免疫细胞,在针对癌症和慢性病产生长期免疫应答中发挥关键作用。这类被称为ID3+ T的细胞因其含有同名蛋白,具备自我更新能力和抗衰竭特性,能够持续产生强大的免疫应答。这一发现有望助力克服慢性疾病治疗中的重大挑战之一。
标签


